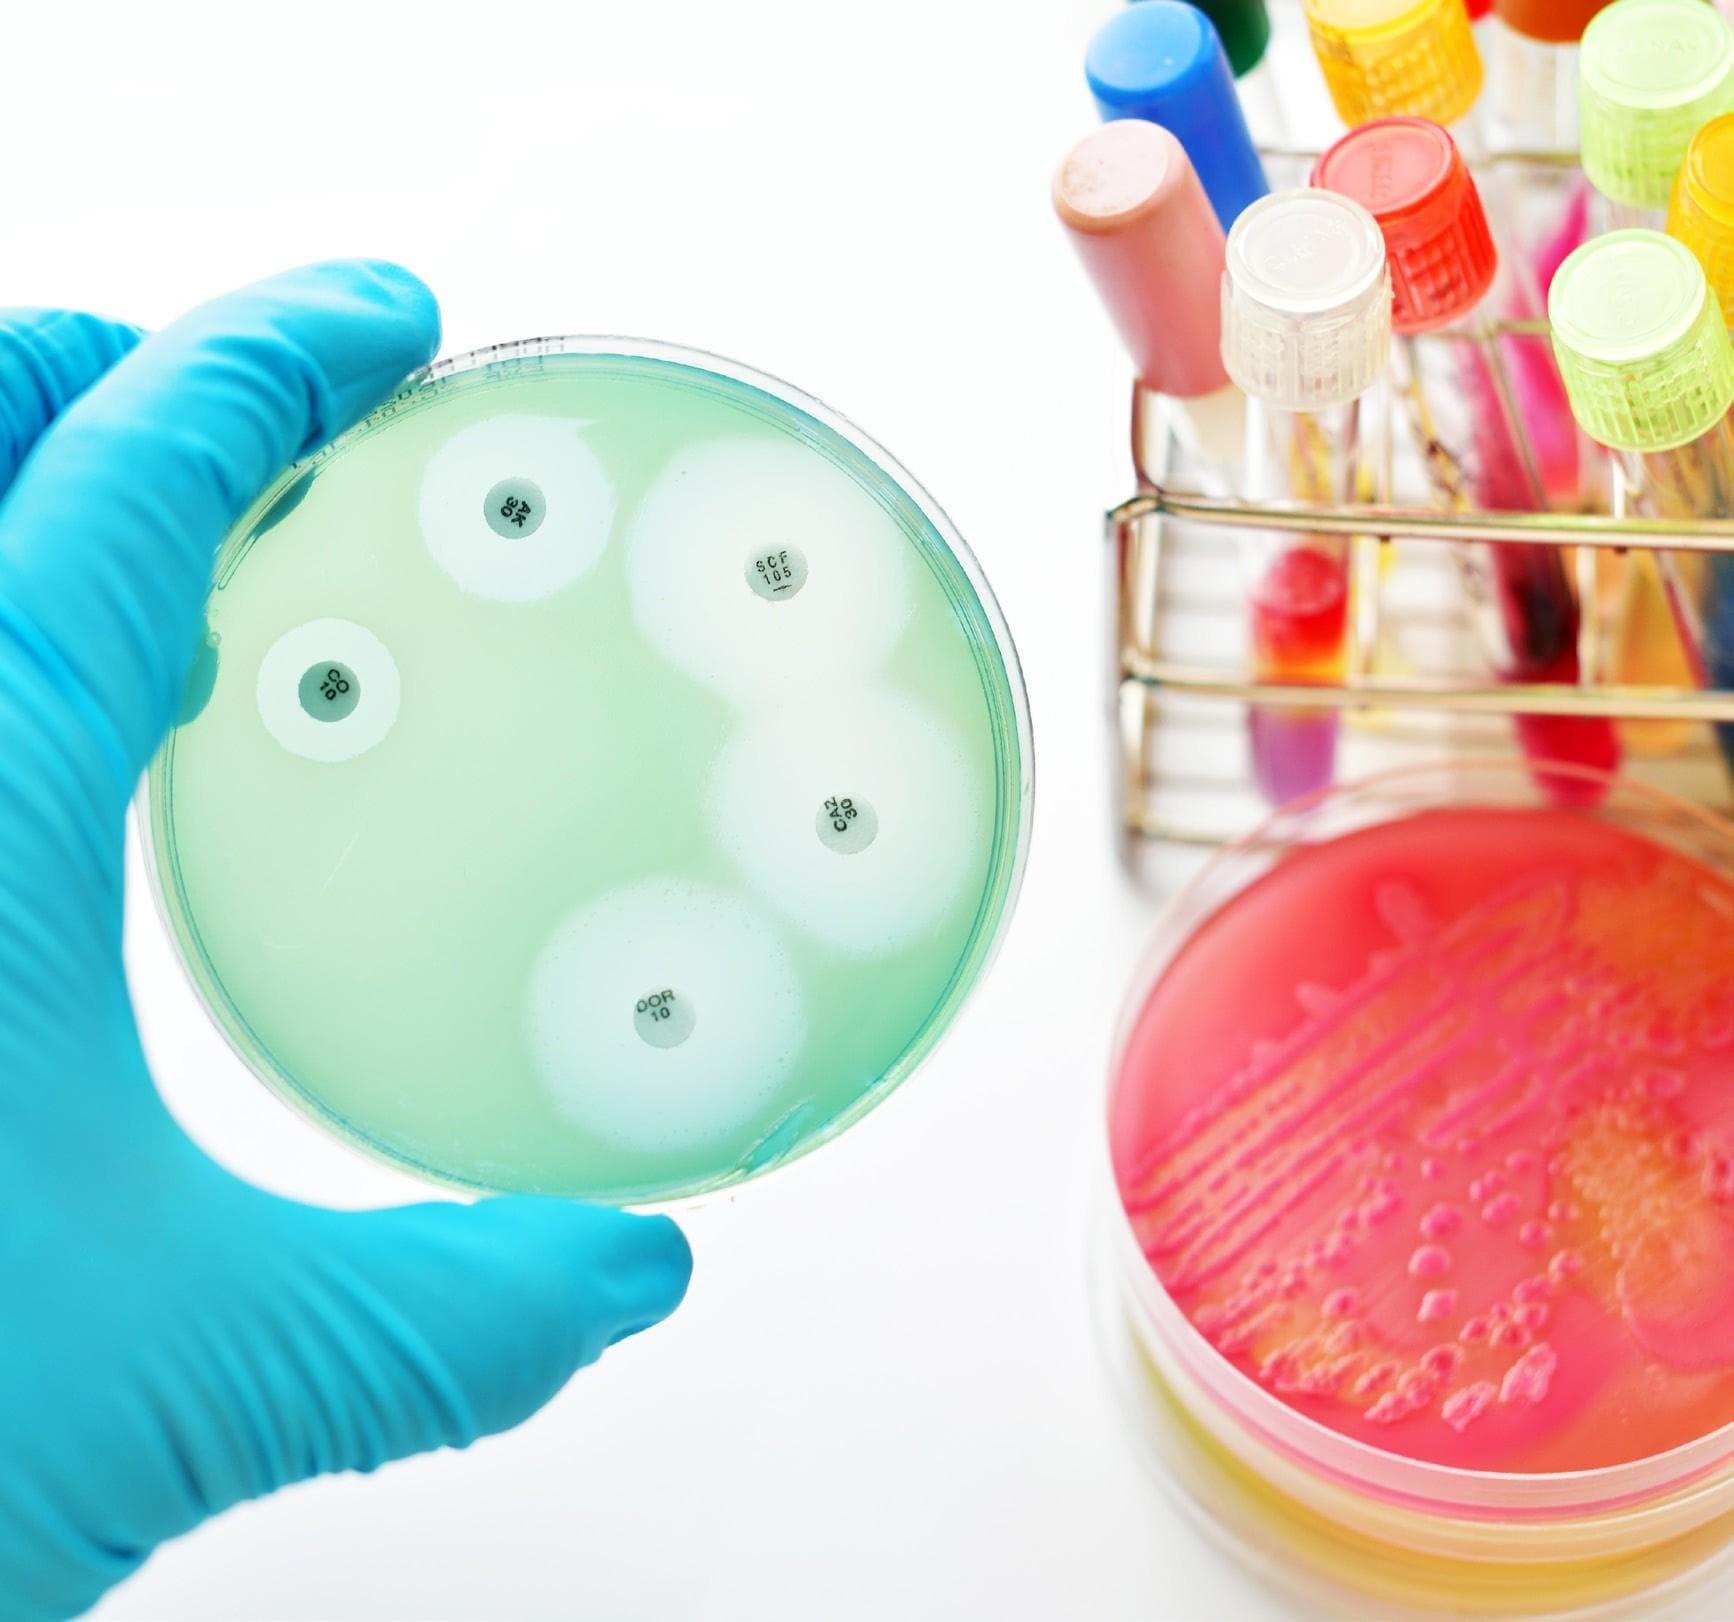
Five facts about antimicrobial resistance

39 articles from this collection:

AstraZeneca’s Truqap plus Faslodex approved by FDA for treatment of breast cancer
AstraZeneca has announced that the US Food and Drug Administration (FDA) has approved Truqap (capivasertib) in combination with Faslodex (fullvestrant) for the treatment of adult patients with hormone receptor (HR)-positive, HER2-negative locally advanced or metastatic breast cancer with one or more biomarker alterations.

ViroCell and Great Ormand Street Hospital receive MHRA manufacturing approval
Virocell Biologics has announced that it can now manufacture and export viral vectors from Great Ormand Street Hospital’s (GOSH) state-of-the-art manufacturing facility, the Zayed Centre for Research, for use in clinical trials.

SAMEDAN
samedan

Contents
Welcome to the December 2023 issue of Pharmafocus!

PharmaRole
Pharmarole.com

CHMP shares positive opinion for GSK’s momelotinib for myelofibrosis treatment
GSK has announced that the CHMP of the EMA has given a positive recommendation to the company’s momelotinib for patients with myelofibrosis.

Novo Nordisk invests 42bn Danish kroner in manufacturing facilities in Kalundborg, Denmark
Novo Nordisk has announced plans to invest over 42bn Danish kroner to expand its existing manufacturing facilities in Kalundbord, Denmark, for production of the company’s current and future product portfolio within serious chronic diseases.

Cell therapy pipeline shared by bit.bio
Bit.bio has announced its cell therapy pipeline as well as having shared its lead cell therapy candidate, preparing to enter clinical development in 2025.

Autifony and Jazz Pharmaceuticals enter global licence and collaboration agreement
Autifony Therapeutics has announced that it has entered an exclusive global licensing agreement with Jazz Pharmaceuticals for up to $770.5m, with the intention of discovering and developing drug candidates to target two different ion channel targets associated with neurological disorders.

GSK’s Ventolin low carbon inhaler to progress to phase 3 trials in 2024
GSK has announced that in 2024 it intends to start phase 3 trials of a low carbon version of its metered-dose inhaler ventolin (salbutamol) using a next-generation propellant.

AstraZeneca’s Imfinzi meets primary endpoint for liver cancer treatment
AstraZeneca has announced positive results from the EMERALD-1 phase 3 trial for Imfinzi (durvalumab) in combination with transarterial chemoembolisation and bevacizumab for the treatment of patients with hepatocellular carcinoma eligible for embolisation.

New data shared for Leqembi as Alzheimer’s treatment
Eisai and Biogen have announced that Eisai has shared new data for Leqembi (lecanemab-irmb) 100mg/ml injection for intravenous use at the 16th annual clinical trials on Alzheimer’s disease conference in Boston, US on 24-27 October 2023.

Boan Biotech enrols first patient for Nivolumab phase 3 trial in China
Boan Biotech has announced that the first patient has been enrolled in its phase 3 trial of its nivolumab injection (ba1104) in china.

PharmaTimes
Www.pharmatimes.com/intcr

Merck’s Keytruda approved by FDA for gastric cancer treatment
Merck, known as MSD outside of the US, has announced that the FDA has approved Keytruda in combination with fluoropyrimidine- and platinum-containing chemotherapy, for first-line treatment of adult patients with locally advanced unresectable or metastatic her2-negative gastric or gastroesophageal junction adenocarcinoma.

BMS’s Augtyro approved by FDA for lung cancer treatment
Bristol Myers Squibb has announced that the FDA has approved Augtyro (repotrectinib) for the treatment of adult patients with locally advanced or metastatic ros1-positive non-small cell lung cancer.

Pharmafile
Www.pharmafile.com

EC approves Daiichi Sankyo’s Vanflyta for acute myeloid leukaemia treatment
Daiichi Sankyo has announced that Vanflyta (quizartinib) has been approved in the EU for combination use with standard cytarabine and anthracycline induction and standard cytarabine consolidation chemotherapy for adult patients with newly diagnosed acute myeloid leukaemia that is flt3-itd positive.

FDA approves Eli Lilly’s Zepbound for chronic weight management
Eli Lilly has announced that the FDA has approved Zepbound (tirzepatide) injection for chronic weight management, indicated for patients who are obese or overweight and have weight-related medical problems such as hypertension, dyslipidaemia, type 2 diabetes mellitus, obstructive sleep apnoea or cardiovascular disease.

J&J plans to submit surgical robot to regulators in 2024
Johnson & Johnson Medtech has announced plans to submit the Ottava robotic surgical system to the FDA for an investigational device exemption application in the second half of 2024.

AstraZeneca and Cellectis announce collaboration for cell therapy and genomic medicine development
AstraZeneca has announced a collaboration and investment agreement with Cellectis for the development of next-generation cell and gene therapeutics in areas such as oncology, immunology and rare diseases.

Evotec and Dewpoint Therapeutics announce that they will enter strategic partnership
Evotec and Dewpoint Therapeutics have announced a strategic R&D collaboration for the advancement of Dewpoint’s oncolo y pipeline programmes of condensate-modifying therapeutics to investigational new drug applications through the use of Evotec’s fully integrated data-driven platform.

Halozyme and Acumen Pharmaceuticals collaborate for Alzheimer’s treatment
Halozyme Therapeutics has announced a global collaboration and non-exclusive licence with Acumen Pharmaceuticals, providing Acumen with access to Halozyme’s ENHANZE drug delivery technology.

Innovations in Pharmaceutical Technology
Www.iptonline.com

Roche to acquire Telavant for $7.1bn
Roche has announced that it has entered into a definitive agreement to acquire Telavant Holdings, a Roivant company, owned by Roivant sciences and Pfizer.

Propella Therapeutics to be acquired by Astellas Pharma for $175m
Astellas Pharma and Propella Therapeutics have announced that they have entered a merger agreement in which Astellas will acquire Propella for approximately $175m.

Fresenius Kabi’s manufacturing site to be acquired by Prange Group and Adragos Pharma
Prange Group and Adragos Pharma have announced the signing of definitive agreements with Fresenius Kabi for their acquisition of its leading sterile pharmaceutical production site in Halden, Norway.

SAMEDAN
www.samedanltd.com

Embracing technological advancements: revolutionising clinical trials through remote capabilities
Dr Harsha Rajasimha from Jeeva Informatics considers how digital innovations and decentralisation can improve clinical trials

Anti-counterfeiting: the battle against fake pharmaceuticals
Steve Brownett-Gale, marketing lead at Origin, considers how to combat counterfeiting in the pharma industry

Notable tech-enabled solutions advancing clinical trials with all stakeholders in mind
Monika Lamba Saini, Greg Lever and Ashley Polhemus from IQVIA and Q2 Solutions explore digital health technologies and their use in clinical trials

International fertility experts appointed to Oxolife’s Scientific Advisory Board
Oxolife has announced that it has appointed globally renowned fertility experts to its scientific advisory board.

NanoSyrinx appoints Anthony Johnson as non-executive director
NanoSyrinx has announced the appointment of Anthony Johnson MD to its board as non-executive director.

Hazel Jones appointed as Enhanc3D Genomics’ chief operating officer
Enhanc3D Genomics has announced the appointment of Hazel Jones as chief operating officer.

IO Biotech appoints Helen Collins to board of directors
IO Biotech has announced the appointment of Helen Collins MD to its board of directors.

The biggest news of 2023
Betsy Goodfellow from Pharmafocus looks back at 2023 and reviews some of the biggest pharma news of the year
Five facts about antimicrobial resistance
Read on for five key facts about AMR.

Pharmafocus
Get in touch @pharmafocus

Pharmafile
Www.pharmafile.com
